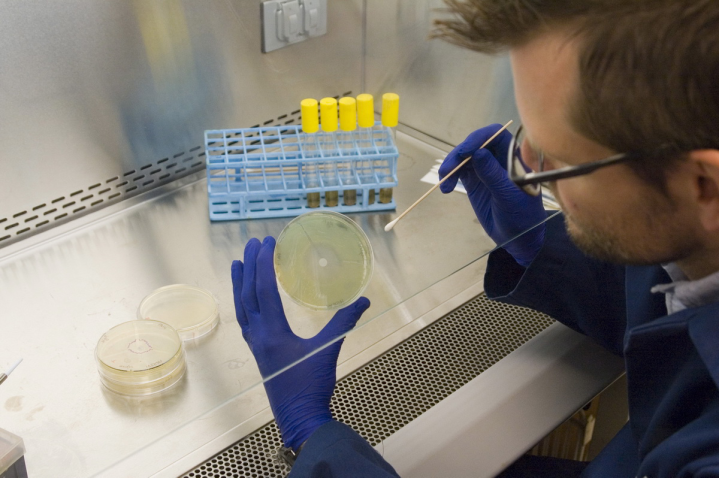

Νανο-υλικά στη μάχη των μικροβίων
Λύσεις μελετά η Ford και το πανεπιστήμιο του Michigan
- -
- -
Τους αόρατους μικροοργανισμούς έχει βάλει σκοπό να αντιμετωπίσει η Ford σε συνεργασία με τους ερευνητές του Πανεπιστημίου του Michigan. Στα αυτοκίνητα βρίσκουν καταφύγιο μικρόβια όπως η μούχλα που μπορούν εκτός των μολύνσεων, μπορούν να προκαλέσουν αποχρωματισμό των επιφανειών και δυσάρεστη οσμή. Η εταιρεία Mintelπραγματοποίησε έρευνα αγοράς όπου προέκυψε ότι οι Αμερικανοί ξοδεύουν 2,3 δις δολάρια ετησίως στο αυτοκίνητό τους για αποσμητικά χώρου, μπαταρίας, αεροζόλ κλπ. Όμως πολλοί καταναλωτές έχουν ευαισθησία στα χημικά που χρησιμοποιούν τα αποσμητικά και επιθυμούν μια πιο δραστική λύση η οποία θα εξαλείφει την πηγή της δυσάρεστης οσμής.
Οι ερευνητές συνέλεξαν δείγματα από το εσωτερικό διαφόρων οχημάτων για ανάλυση στο εργαστήριο. Πήραν επιχρίσματα από το τιμόνι, τα κουμπιά του ραδιοφώνου και του λεβιέ ταχυτήτων. Τα αποτελέσματα έδειξαν υψηλές συγκεντρώσεις βακτηρίων κυρίως στο τιμόνι και στις ποτηροθήκες για ευνόητους λόγους.
Οι Αμερικανοί επίσης ξοδεύουν ένα δις δολάρια ετησίως για καθαριστικά και απολυμαντικά για να καταπολεμήσουν τα μικρόβια στο αυτοκίνητό τους. Οι ερευνητές ήρθαν σε επαφή με τους προμηθευτές χρωμάτων καμπίνας όπως η Red Spot Paint και την εταιρεία παραγωγής πρόσθετων Sciessent LLC για να δημιουργήσουν το κατάλληλο υλικό που θα εξολοθρεύει τα μικρόβια. Κατέληξαν σε τρία κοινά χρησιμοποιούμενα υλικά όπως τα ιόντα αργύρου, με την εμπορική ονομασία Agion® κι άλλα υλικά όπως το άλας αμμωνίου και το κερί πολυολεφίνης με νανο-πρόσθετα αργύρου. Τα υλικά αυτά θα χρησιμοποιηθούν σε αυτοκίνητα δοκιμής ώστε να διαπιστωθεί η αντοχή των υλικών στην πάροδο του χρόνου και φυσικά πόσο διατηρούν την αντιμικροβιακή τους δράση.

και στη συνέχεια 'Προσθήκη στην οθόνη αφετηρίας'